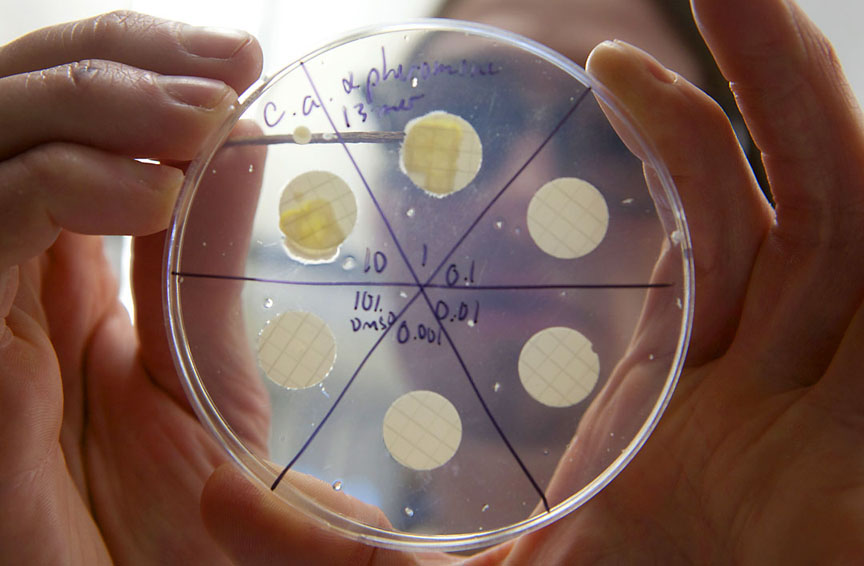
image

Существует огромное количество заболеваний, способных причинить человеку опасность, особенно беззащитны перед ними дети, потому что несформировавшийся организм не может дать достойный отпор серьёзному недугу. Дело в том, что иммунная система ребенка ещё только формируется, следовательно, она не выполняет всех своих функций по защите организма. Молочница на языке у ребенка является одной из достаточно распространенных проблем в таком возрасте. Также данную проблему называют кандидомикозным стоматитом, так как его вызывают дрожжеподобные грибки, относящиеся к роду Candida.
Отметим, что по ранее описанным причинам, то есть из-за постепенного развития иммунитета, с данной проблемой чаще всего сталкиваются новорождённые дети, с возрастом риск поражения такого рода заметно уменьшается. Молочница на языке всегда проявляется в виде бугорков, имеющих творожистую консистенцию, под которыми скрываются скопления грибков. Опытный врач без особого труда сможет помочь справиться с этой проблемой, важно только своевременно обратиться за медицинской помощью!
Причины развития
Грибок рода Candida, который уже был упомянут ранее, находится внутри любого организма, но с проявлением молочницы сталкиваются далеко не все люди. На самом деле, проблема кроется в иммунной системе, которая без труда подавляет развитие грибка при нахождении человека в здоровом состоянии, но перестаёт выполнять свои функции при развитии нарушений. Вот список основных причин развития этой проблемы:
- Ослабление иммунной системы. Как уже было сказано ранее, в превосходящем большинстве случаев проблема кроется именно в иммунной системе человека, что почти всегда происходит из-за негативного воздействия болезни, осложнений хирургических вмешательств, недостатка необходимых веществ (макроэлементов, микроэлементов, витаминов), расстройства пищеварительной системы и из-за многого другого. Иммунная система может быть ослаблена из-за недоношенности ребенка, а также от молочницы нередко страдают те дети, которые были переведены на искусственное вскармливание с самого рождения.
- Приём сильнодействующих антибиотиков. Негативное влияние сильнодействующих медикаментозных препаратов уже не раз доказывалось. Дело в том, что антибиотики уничтожают не только вредные бактерии, но и полезную микрофлору человеческого кишечника, а это в итоге приводит к снижению функций иммунной системы, следовательно, вредные микроорганизмы начинают активно размножаться, причём рассматриваемые грибки не являются исключением. Специалисты отмечают, что молочница на языке может появиться у ребёнка из-за того, что антибиотики принимала его мать, из-за чего их действующие вещества передались ему через грудное молоко.
- Нарушения простейших правил личной гигиены. Правила гигиены — это именно то, что позволяет человеку оставаться здоровым, они являются важнейшим средством профилактики любых болезней. При нарушении даже простейших правил молочница станет минимальной проблемой, с которыми может столкнуться ещё неокрепший организм. Важно мыть малышу руки, очищать все игрушки, постоянно мыть соску и ни в коем случае не засовывать её обратно в рот, поднимая с пола.
- Злоупотребление сладкой пищей. Данный фактор, как и все предыдущие, способен вызвать далеко не одну молочницу на языке, но и массу других проблем со здоровьем. В любом случае, высокий уровень глюкозы стимулирует размножение грибков и образование ими огромных колоний. Дело в том, что сладкая среда позволяет обеспечить идеальные условия для их развития. Ваша задача заключается в правильном подборе смеси для питания малыша, а также других продуктов, если он их уже употребляет.
- Наличие молочницы у матери во время беременности. Далеко не все женщины осведомлены, что их болезни могут как-либо переходить детям. Дело в том, что инфицирование грибком рода Candida возможно уже тогда, когда ребенок находится в утробе матери. Случается же это в тех ситуациях, когда во время беременности девушка сталкивается с молочницей полового органа, то есть с заболеванием под названием вагинальный кандидоз. Специалисты отмечают, что такой ситуации можно без труда избежать, если своевременно обратиться к квалифицированному специалисту, который позволит быстро и безопасно избавиться от проблемы, но так как многие девушки пренебрегают этим советом, проблема нередко передаётся их чаду.
- Постоянные срыгивания. Да, проблема может заключаться и в регулярных срыгиваниях, что закончится появлением серьёзного раздражения слизистой оболочки. Таким образом, во рту будет создана кислая среда, которая также благоприятно повлияет на развитие молочницы ребенка. То же самое можно сказать и про возникновение травм в ротовой полости, потому что они могут вызывать подобные нарушения.
- Проблемы, связанные с кормлением. Иногда по различным причинам вскармливание грудью может начаться довольно поздно, что, как несложно догадаться, также может стать причиной развития рассматриваемой проблемы. Специалисты утверждают, что вы должны осуществлять кормление с самого первого дня.
- Негативное влияние внешних условий. Такие факторы, как повышенная температура и пониженная влажность воздуха, могут вести к серьезным нарушениям у ребенка, а именно — к пересыханиям слизистой оболочки. Дело в том, что количество слюны значительно уменьшается, а она необходима, так как в ней находится обеззараживающее вещество, способное существенно задерживать развитие вредных микроорганизмов. По этой причине болезнь начинает распространяться крайне стремительно. В подобных случаях проблема чаще всего решается увлажнением слизистой оболочки посредством применения специальных капель или даже других средств, также иногда бывает необходимо использовать увлажнитель воздуха и контролировать температуру. Важно понимать, что всё должно быть в меру, многие очень сильно увеличивают влажность, что также довольно негативно сказывается на состоянии ребенка, идеальный показатель — 50-60%.
Вам ни в коем случае не следует самостоятельно искать причину развития этой проблемы, при появлении негативных проявлений, которые будут описаны ниже, важно максимально быстро обратиться к квалифицированному специалисту. В противном случае, вы потеряете драгоценное время, которое могло бы пойти на диагностику и начало терапии.
Симптоматика на разных стадиях
Молочница на языке ребенка развивается достаточно быстро, несмотря на это врачи выделяют три стадии, на которых наблюдаются различные проявления:
- Лёгкая. В это время болезнь только начинает развиваться, ведь проявляется она не сразу. Единственным первым симптомом является образование творожистых крупинок белого цвета на языке и внутренних сторонах щек. На этом этапе малыша ещё не будут тревожить сильные неприятные ощущения, вы не будете замечать запахов, а сам налёт можно будет легко удалить языка или щёк при помощи ватной палочки или чего-либо ещё.
- Средняя. На второй стадии будет наблюдаться уже не только творожистый налет, поражение приобретет плёнчатый характер, то есть вы уже не сможете так просто его удалить. Проблема начнет распространяться также на губы и на нёбо, поэтому вы точно не сможете пропустить её. Отметим, что на этом этапе начнут появляться неприятные ощущения, а при попытке убрать возникший налёт может начаться кровоточение слизистой оболочки.
- Тяжёлая. На этом этапе начнут прогрессировать все проявления, а состояние ребенка — ухудшаться. Обращаться к врачу следует на более ранних этапах развития проблем, в это время плёнка уже совсем не будет собираться и покроет всю ротовую полость, что в итоге может привести к серьёзным осложнениям или даже к смерти при отсутствии медицинской помощи и на этом этапе.
Лечение
Как уже было упомянуто ранее, справиться с рассматриваемой проблемой достаточно просто, но только в том случае, если обращение к врачу будет своевременным. Давайте рассмотрим основные принципы терапии по возрастам ребенка.
До 6 месяцев
Болезни у новорождённых детей лечатся тяжелее всего. Дело в том, что в раннем возрасте ни в коем случае нельзя использовать сильнодействующие лекарственные препараты, так как они способны очень серьезно ухудшить состояние ребёнка. Как уже было сказано ранее, основная задача матери заключается в своевременной консультации с врачом.
Например, при появлении большого количества отрыгиваний необходимо нормализовать процесс кормления. Для этого нужно научиться грамотно прикладывать к груди малыша, а также следить за его положением в процессе всего кормления. После этого немного подержите ребёнка в прямом состоянии, теперь оставьте его на определённое время в покое. Таким образом, удастся свести к минимуму риск срыгивания.
В любом случае борьба с заболеванием всегда в первую очередь направлена на устранение причин его развития. Например, если произошло ухудшение работы иммунной системы, то необходимо выяснить причины возникновения таких нарушений и как-либо стимулировать её.
От 6-12 месяцев
Когда ребёнок достигнет возраста 6 месяцев ему уже можно будет использовать некоторые медикаментозные препараты. По этой причине процесс лечения заметно облегчится. Действие этих средств обычно заключается в создании щелочной среды и в дезинфицирующем эффекте, что в комплексе способно помочь успешно побороть грибок.
Профилактические меры
Вылечить молочницу на языке у ребенка не всегда бывает достаточно, ведь для того, чтобы предупредить её появление в будущем требуется соблюдать профилактические меры. Вот основные из них:
- Старайтесь всегда прокипятить то, что ребёнок может засунуть в рот, например, соску, бутылку, любимую игрушку или какой-нибудь другой предмет. Это лучше, чем ругать малыша за это, таким способом он познаёт мир!
- Постоянно мойте руки ребенку, а также купайте и подмывайте его, ведь правила гигиены очень важны.
- Своевременно меняйте одежду и постельное бельё малыша.
- Важно следить за гигиеной кормящим матерям, а также необходимо постоянно обрабатывать молочные железы (в большинстве случаев для этого применяется содовый раствор, но данный момент лучше всего индивидуально обговорить с врачом).
- После кормления необходимо будет немного попоить его водой и прополоскать ему рот. Вода обязательно должна быть теплой и кипяченой. Таким образом, вам удастся очистить полость рта от оставшейся еды.
- Больше гуляйте с ребёнком, дышите свежим воздухом.
- Проводите в помещении влажные уборки, следите за влажностью воздуха и за температурой.

Лечение может назначать только квалифицированный специалист с большим опытом работы, самолечение практически всегда заканчивается печально. Дело в том, что так вы только потеряете время, не достигнув необходимого эффекта!
Частые вопросы
Какие способы лечения молочницы на языке у ребёнка существуют?
Существуют различные способы лечения молочницы на языке у ребёнка, включая применение антимикотических препаратов, местное лечение гелем или кремом, а также коррекцию питания и гигиенические меры.
Как определить, что у ребёнка молочница на языке?
Молочница на языке у ребёнка может проявляться в виде белого налета или пятен на языке, сопровождаться зудом или болезненностью. Для точного диагноза необходимо обратиться к врачу.
Каковы основные принципы профилактики молочницы на языке у ребёнка?
Основные принципы профилактики молочницы на языке у ребёнка включают поддержание хорошей гигиены полости рта, правильное питание, укрепление иммунитета и своевременное обращение к врачу при первых признаках заболевания.
Полезные советы
СОВЕТ №1
Обратитесь к педиатру или детскому стоматологу для точного диагноза и назначения лечения молочницы на языке у ребёнка.
СОВЕТ №2
Следуйте рекомендациям врача относительно применения антимикотических препаратов, местных противогрибковых средств или промывания рта специальными растворами.
СОВЕТ №3
Соблюдайте гигиену полости рта ребёнка, регулярно чистите язык и зубы, чтобы предотвратить повторное появление молочницы.